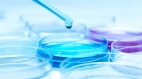
亦师‧亦父‧亦友(图)

- 吃早餐的禁忌 这3种食物最不该吃(组图)
- 徐佳莹晒10年前无P图沙龙照 青涩模样惊呆网友(组图)
- 日本人的长寿味噌汤 每天一碗抗氧化养颜美容(组图)
- 抹香鲸排泄物 人们求之不得的发财机会(视频)
- 约满《关键时刻》选立委?刘宝杰回应了(图)
- 肩膀疼痛就是肩周炎吗?4个缓解小动作(图)
- 陈年污垢洗不掉?一个天然小物让电锅闪闪发亮(视频)
- 阿里山“邹族”最年轻的部落-逐鹿部落(组图)
- 血瘀气滞易生病 4款食疗活血化瘀(图)
- 什么脾气什么命(组图)
- 夜夜失眠睡不着 快来学美军“2分钟熟睡法”(图)
- 肝脏最爱这5种食物帮它排肝毒 你吃了吗?(组图)
- 【按穴疗法】足跟痛(组图)
- 太经典了!父母与子女的对谈(组图)
- 选前挺韩“100场免费”冯翊纲选后改口:要有人出钱(图)
- 这些习惯正在悄悄偷走你的钙(组图)
- 身高不是距离 蔡昌宪席开百桌迎娶高个子娇妻(组图)
- 中国男星施暴日籍女友 登日媒大头条(组图)
- 范冰冰逃税事件延烧 好莱坞大梦已碎(组图)
- 降胆固醇降血糖 聪明吃燕麦让您精神焕发(组图)